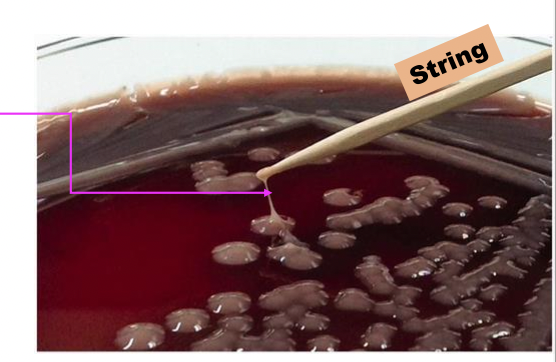
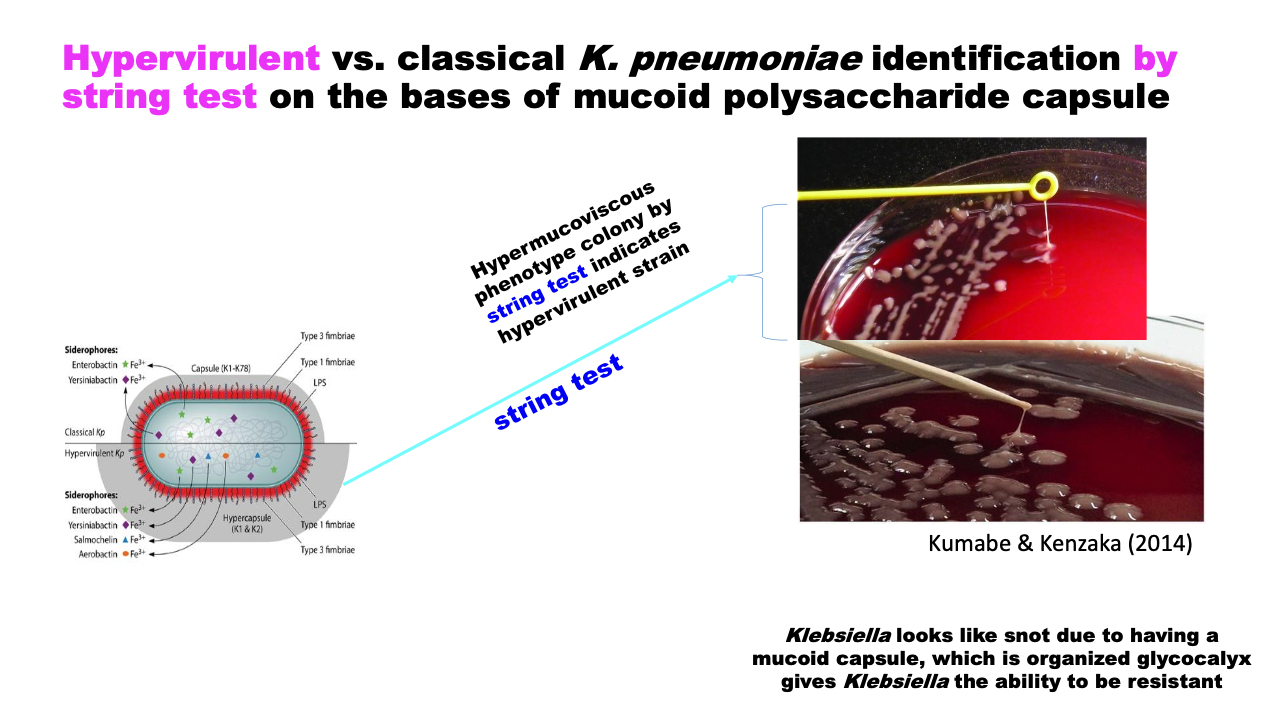

Are coliforms lactose fermentors or lactose nonfermentors?
Lactose fermentors
Coliforms are apart of CEEK.
Citrobacter
Enterobacter
Klebsiella

Name the sites of colonization and extraintestinal disease production by coliforms and Proteus.

Name the three important species of Klebsiellla. Which of these members are apart of ESKAPE?
Three species are super important
1. K. aerogenes
2. K. pneumoniae
3. K. oxytoca
K. aerogenes, K. pneumoniae
Which strains of Klebsiella are resistant to Carbapenem?

Klebisella is gram _______
negative
Klebsiella has what type of antigen?
Somatic O antigen aka has LPS
Is Klebsiella a lactose fermentor or lactose nonfermentor?
Lactose fermentor.
Klebsiella
Highly mucoid colony due to very
thick capsule
Is Klebsiella Motile?
Non-motile (no flagella) (unlike Enterobacter)
Thus, do not have flagella or H antigen
Does Klebsiella produce H2S gas?
No
Is Klebsiella urease positive or negative?
Urease positive, unlike enterobacter
How many different O antigens/serotypes does Klebsiella have?
8 to 11
How many different K antigens or K serotypes does Klebsiella have?
Capsule
Two K. pneumoniae types by the size of their capsule
- Classical K. pneumoniae (top) vs.
- hypercapsulated hypervirulent (bottom) K. pneumoniae strains
Hypervirulent vs. classical K. pneumoniae identification by string test on the bases of mucoid polysaccharide capsule
Name the major virulence factors of Klebsiella

What is the activity of capsular (slime layer)?
Evade phagocytosis and immune evasion
What is the activity of lipopolysaccharides?
Evade serum killing factors & phagocytosis (endotoxin)
What is the activity of adherence factors (type 1 fimbrae)?
Adhere to host surfaces & for conjugative plasmid exchange
What is the activity of biofilms?
Survive in harsh environment
What is the activity of outer membrane proteins?
Protect bacteria from the effect of antimicrobials
What is the activity of siderophores?
Rob iron from the host cell











